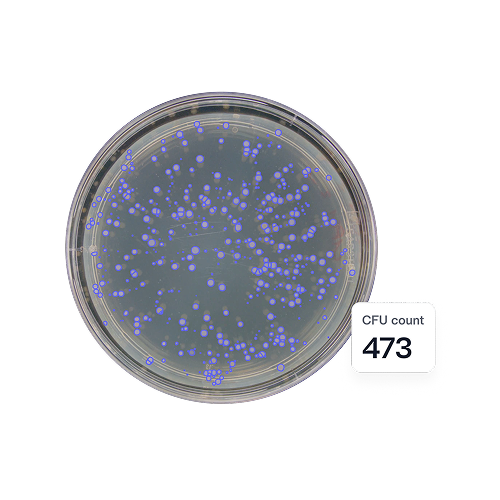
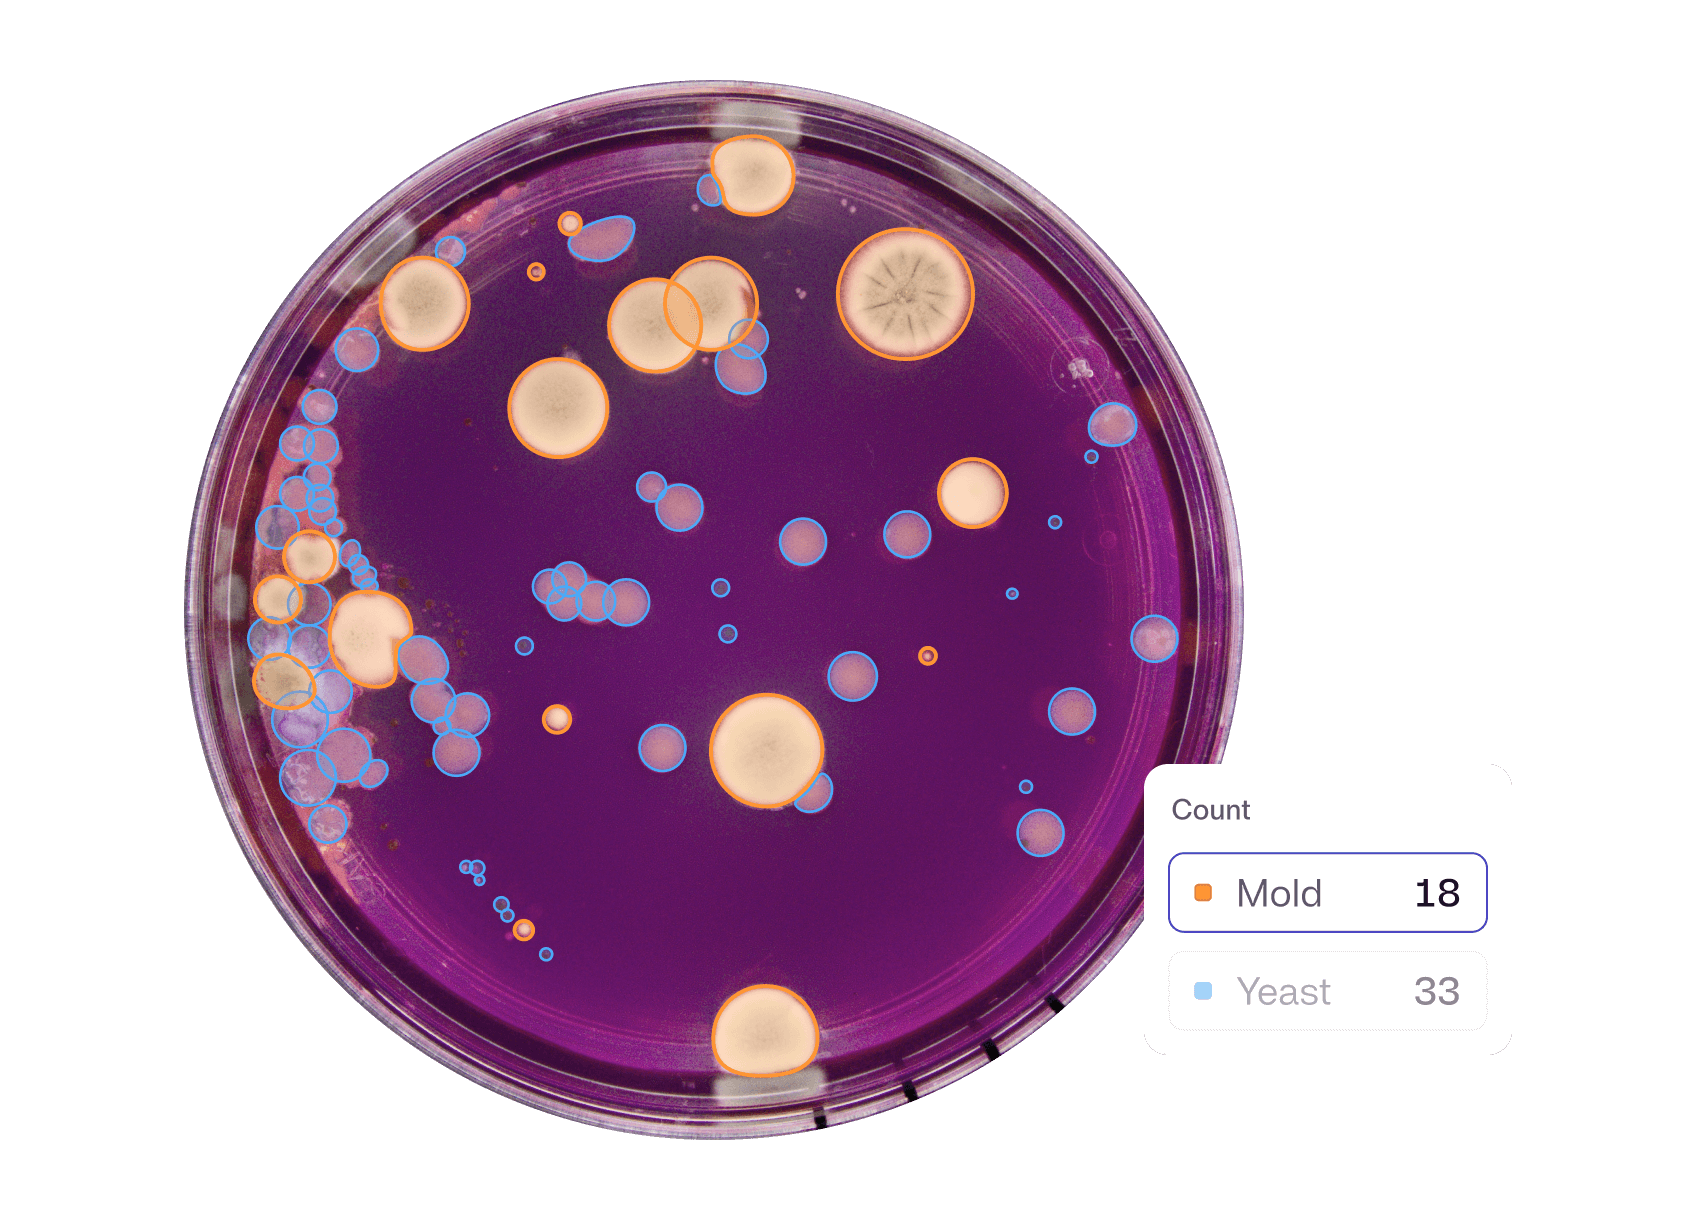

Accelerate Personal Care R&D with AI-powered Automation
Automate testing and analysis of cosmetics and personal care ingredients and products to ensure product quality, safety, and efficacy.

“With the help of Reshape, we have moved further in improving the workflow in 6 months than in the 3 years before with other solutions we tried.”
“Getting deep insights into everything that happens during our experiment is hugely helpful to discover new phenomena more quickly.”
"The Reshape system has revolutionized how we screen and study microbial clones. We can now track metabolite production, release, and diffusion at an unprecedented scale.”

Manual methods and outdated equipment hinder progress
Personal care R&D demands rigorous testing for safety, shelf-life, and efficacy. Manual inspections introduce variability, slow timelines, and limit scalability.
Control experiment parameters and produce objective, reliable and high-quality data that enables you to make decisions with confidence and clarity.

Standardize image input
Keep imaging conditions the same at all times. Capture single-point images or time-lapse images using three lighting presets.

Trust your data
Gain new levels of accuracy with analysis models continuously being trained on more than 40 million—and counting—images.

Always bias-free
Analysis models don’t get tired, don’t get influenced and are immune to external circumstances. Your results are always 100% objective.

Documentation on autopilot
All results, metadata, and images are logged automatically. Get clean, structured documentation from day one without lifting a finger.




Reshape Discovery Platform
AI models that turn every assay into objective, digital data
From growth kinetics and viable counts to inhibition zones, fluorescence, and morphology, our AI models gives you results faster, with data that’s rich and reliable.
Explore DiscoveryTotal viable count
Quantify microbial load in experiments such as soil samples, biostimulants, or seed coatings to ensure consistent CFU delivery in field applications.

Differential counts
Differentiate microbes such as target strains from contaminants in mixed or complex samples.

Growth Kinetics
Monitor growth performance of strains under different conditions.


Insects
High throughput insect screening to evaluate efficacy of various treatments and determine outputs such as dose response, mortality rates, health scoring, and overall activity.


Colorimetric
Quantify enzyme activity or other color-indication–based responses.


Preservative Testing
Assess stability of biological products during storage and handling.


Media Optimization
Refine growth conditions for agricultural microbial production.


Move faster, minimize setbacks
Manual processes and messy data shouldn’t slow your team down. Reshape automates imaging and analysis so you can focus on what matters and keep your research moving forward.




Capture data 24/7
Don’t let office hours slow down your results. Automated image capture and analysis makes your pipeline work all day, every day.

Precision you can trust
High-resolution imaging and accurate, objective analysis give you consistent results you can rely on. Keep up your momentum without second-guessing.
Plates, trays, dishes – you name it
From petri dishes to omnitrays to microtiter plates – all the way down to 384 wells, we’re ready to handle whatever plate format you’re working with.

No more do-overs
Accurate, continuous data capture from the start helps you avoid wasted cycles and costly repeat experiments.
Fast-track discovery with AI-powered insights
Our smart analysis models automate data extraction and streamline how you conduct experiments, so your R&D team can move faster – and make smarter calls.











